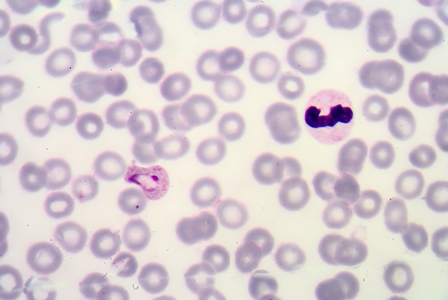
malaria700b

New 20 minute test diagnoses hidden heart condition
Tue, 25 Sep 2018 19:00:00 BST
Cutting-edge electron microscope revealed at opening of new £5m structural biology centre
Tue, 11 Sep 2018 12:00:00 BST

University of Glasgow to share in £80m quantum tech funding boost
Fri, 07 Sep 2018 09:12:00 BST

UK Research and Innovation launches new Mental Health Networks, including UofG-led TRIUMPH Network
Thu, 06 Sep 2018 07:00:00 BST

Funding to UK researchers to help communities and their river hit by illegal mining
Mon, 03 Sep 2018 10:00:00 BST